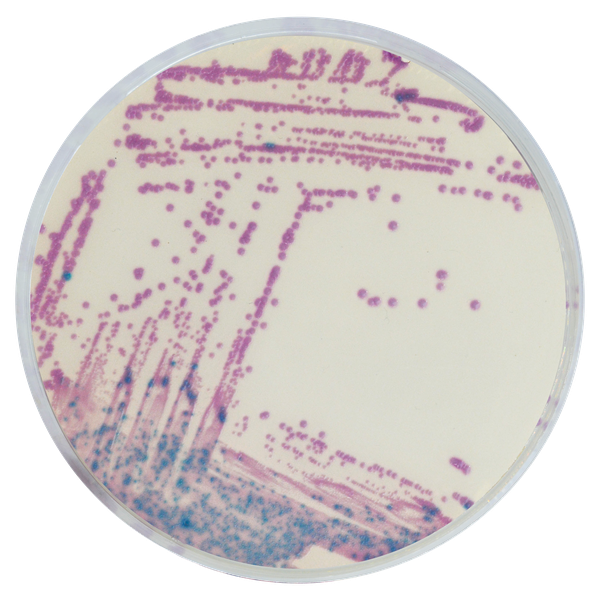
LIM RambaQUICK™ StrepB

Colonies Appearance

Group B Streptococcus
Mauve

Others microorganisms
Blue, colourless or inhibited
Performance
Performance
The CDC recommends pregnant women to be tested at 35 to 37 weeks of pregnancy for Group B Streptococcal (GBS) carriage by selective enrichment broth of vaginal/anorectal swab samples, followed by subculture. However, the selective broth formulas are not dedicated to the inhibition of Enterococci, usually part of the anorectal flora and able to hide the growth of GBS, source of false negative results.
LIM RambaQUICK™ StrepB is a selective enrichment broth designed to largely reduce the growh of Enterococci, while allowing growth of GBS, and, therefore to raise the sensitivity of the prepartum screening method.
Compared to classical LIM + subculture method:
1. Inhibition of most Enterococci : LIM RambaQUICK™ StrepB is a selective enrichment broth designed to largely reduce the growth of Enterococci, while allowing growth of GBS, and, therefore to raise the sensitivity of the prepartum screening method.
2. Broth inoculation : Classical Method recommends overnight broth incubation for classical LIM. LIM RambaQUICK™ StrepB can be used also with overnight incubation, but has an optimal differentiation at 6h only as suggested in the Dr. Poisson Method study.
Study : Filtration pré-partum du groupe vaginal / anorectal Filtrage des streptocoques: amélioration de l’étape d’enrichissement par le bouillon d’additif RambaQUICK StrepB; D. Poisson et al. Centre Hospitalier Régional Orleans, France; Journal de Méthodes de Microbiologie 89 (2012) 107-109 doi:10.1016/j.mimet.2012.02.012
3. Easy interpretation of the subculture plate : Easier reading of CHROMagar™ StrepB plate thanks to an intense mauve colony colouration.
Composition
Technical Documents
Scientific Publications
2014
Comparison of culture-based methods for Group B Streptococcus detection in screening samples from pregnant women
📄 Publication2012
Prepartum vaginal/anorectal Group B Streptococcus screening: Improvement of the enrichment step by the broth additive RambaQUICK StrepB
📄 Publication

Read more